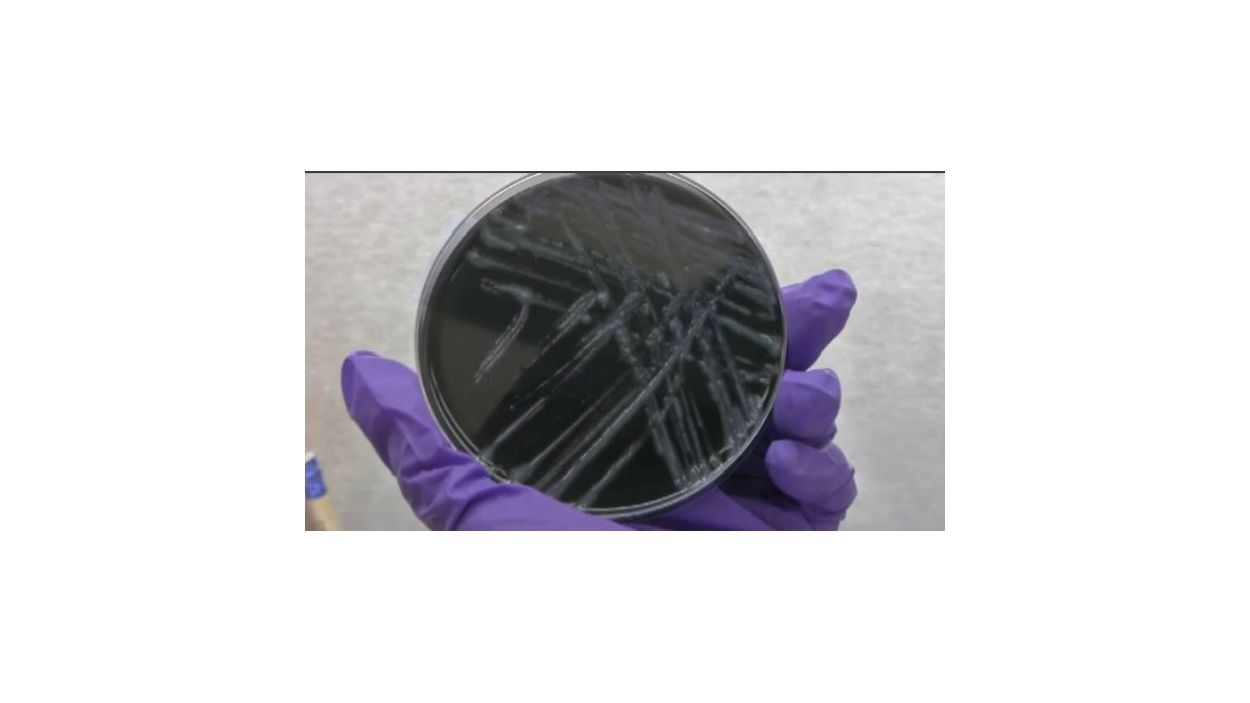

Las autoridades de la ciudad están investigando el posible brote de la enfermedad del legionario en un edificio de apartamentos en Brownsville, Brooklyn.
El Departamento de Salud está evaluando actualmente el sistema de agua del edificio en 335-337 Sutter Avenue.
La agencia y la administración del edificio están alertando a los residentes sobre la situación, y brindando orientación sobre cómo prevenir la exposición.
Especialmente para aquellos con mayor riesgo que incluyen personas de 50 años o más, fumadores, y personas con enfermedades pulmonares crónicas y aquellas con sistemas inmunológicos comprometidos.
El contagio se da al inhalar vapor del agua contaminada con la bacteria.
Por ello, entre las recomaciones se encuentran:
- No ducharse, ni siquiera con agua fría, ya que podría generar vapor de agua. En su lugar llene la bañera lentamente.
- Está bien lavar los platos, pero llene el fregadero lentamente con agua fría para evitar vapor.
- Está bien beber agua fría del grifo.
- Para tomar bebidas calientes, primero use agua fría.
- Es importante seguir lavándose las manos.